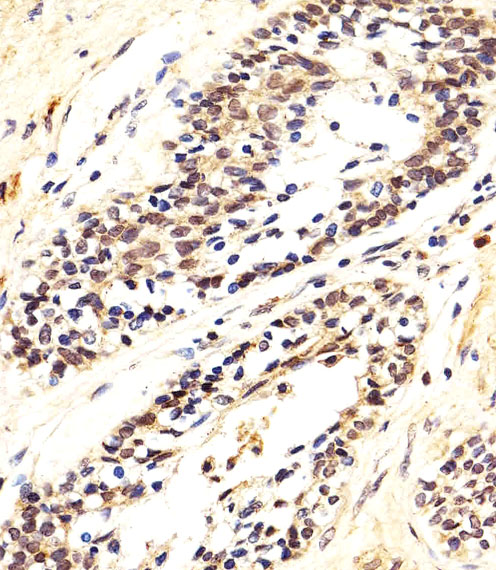

> Antigen, Antibodies, ELISA, Western Blot > Primary Antibody > Polyclonal Antibodies > AKT1/2/3 Antibody (Center)Brand |
Leading Biology | Catalog Number |
AMM08752G |
Product Type |
Polyclonal Antibodies | Field of Research |
|
Product Overview |
We constantly strive to ensure we provide our customers with the best antibodies. As a result of this work we offer this antibody in purified format.
We are in the process of updating our datasheets. If you have any questions regarding this update, please feel free to contact our technical support team.
This product is a high quality AKT1/2/3 antibody (Center).
|
||
Molecular Weight |
H=56;M=56;Rat=56 KDa
|
||
Cellular Localization |
Antigen Cellular Localization:
Cytoplasm. Nucleus. Cell membrane. Note=Nucleus after activation by integrin-linked protein kinase 1 (ILK1). Nuclear translocation is enhanced by interaction with TCL1A. Phosphorylation on Tyr-176 by TNK2 results in its localization to the cell membrane where it is targeted for further phosphorylations on Thr-308 and Ser-473 leading to its activation and the activated form translocates to the nucleus
|
||
Host |
Rabbit
|
||
Species Reactivity |
Human, Rat
|
||
Immunogen |
278-312 aa
|
||
Target |
This AKT1/2/3 antibody is generated from a rabbit immunized with a KLH conjugated synthetic peptide between 278-312 amino acids from the Central region of human AKT1/2/3.
|
||
Symbol |
PKB, RAC
|
||
GeneID |
|||
UniProt ID |
|||
Function |
AKT1 is one of 3 closely related serine/threonine- protein kinases (AKT1, AKT2 and AKT3) called the AKT kinase, and which regulate many processes including metabolism, proliferation, cell survival, growth and angiogenesis. This is mediated through serine and/or threonine phosphorylation of a range of downstream substrates. Over 100 substrate candidates have been reported so far, but for most of them, no isoform specificity has been reported. AKT is responsible of the regulation of glucose uptake by mediating insulin-induced translocation of the SLC2A4/GLUT4 glucose transporter to the cell surface. Phosphorylation of PTPN1 at 'Ser-50' negatively modulates its phosphatase activity preventing dephosphorylation of the insulin receptor and the attenuation of insulin signaling. Phosphorylation of TBC1D4 triggers the binding of this effector to inhibitory 14-3-3 proteins, which is required for insulin-stimulated glucose transport. AKT regulates also the storage of glucose in the form of glycogen by phosphorylating GSK3A at 'Ser-21' and GSK3B at 'Ser-9', resulting in inhibition of its kinase activity. Phosphorylation of GSK3 isoforms by AKT is also thought to be one mechanism by which cell proliferation is driven. AKT regulates also cell survival via the phosphorylation of MAP3K5 (apoptosis signal-related kinase). Phosphorylation of 'Ser-83' decreases MAP3K5 kinase activity stimulated by oxidative stress and thereby prevents apoptosis. AKT mediates insulin-stimulated protein synthesis by phosphorylating TSC2 at 'Ser-939' and 'Thr-1462', thereby activating mTORC1 signaling and leading to both phosphorylation of 4E-BP1 and in activation of RPS6KB1. AKT is involved in the phosphorylation of members of the FOXO factors (Forkhead family of transcription factors), leading to binding of 14-3-3 proteins and cytoplasmic localization. In particular, FOXO1 is phosphorylated at 'Thr-24', 'Ser-256' and 'Ser-319'. FOXO3 and FOXO4 are phosphorylated on equivalent sites. AKT has an important role in the regulation of NF-kappa-B-dependent gene transcription and positively regulates the activity of CREB1 (cyclic AMP (cAMP)- response element binding protein). The phosphorylation of CREB1 induces the binding of accessory proteins that are necessary for the transcription of pro-survival genes such as BCL2 and MCL1. AKT phosphorylates 'Ser-454' on ATP citrate lyase (ACLY), thereby potentially regulating ACLY activity and fatty acid synthesis. Activates the 3B isoform of cyclic nucleotide phosphodiesterase (PDE3B) via phosphorylation of 'Ser-273', resulting in reduced cyclic AMP levels and inhibition of lipolysis. Phosphorylates PIKFYVE on 'Ser-318', which results in increased PI(3)P-5 activity. The Rho GTPase-activating protein DLC1 is another substrate and its phosphorylation is implicated in the regulation cell proliferation and cell growth. AKT plays a role as key modulator of the AKT-mTOR signaling pathway controlling the tempo of the process of newborn neurons integration during adult neurogenesis, including correct neuron positioning, dendritic development and synapse formation. Signals downstream of phosphatidylinositol 3-kinase (PI(3)K) to mediate the effects of various growth factors such as platelet-derived growth factor (PDGF), epidermal growth factor (EGF), insulin and insulin-like growth factor I (IGF-I). AKT mediates the antiapoptotic effects of IGF-I. Essential for the SPATA13-mediated regulation of cell migration and adhesion assembly and disassembly. May be involved in the regulation of the placental development. Phosphorylates STK4/MST1 at 'Thr-120' and 'Thr-387' leading to inhibition of its: kinase activity, nuclear translocation, autophosphorylation and ability to phosphorylate FOXO3. Phosphorylates STK3/MST2 at 'Thr- 117' and 'Thr-384' leading to inhibition of its: cleavage, kinase activity, autophosphorylation at Thr-180, binding to RASSF1 and nuclear translocation. Phosphorylates SRPK2 and enhances its kinase activity towards SRSF2 and ACIN1 and promotes its nuclear translocation. Phosphorylates RAF1 at 'Ser-259' and negatively regulates its activity. Phosphorylation of BAD stimulates its pro- apoptotic activity. Phosphorylates KAT6A at 'Thr-369' and this phosphorylation inhibits the interaction of KAT6A with PML and negatively regulates its acetylation activity towards p53/TP53.
|
||
Summary |
AKT1 is one of 3 closely related serine/threonine- protein kinases (AKT1, AKT2 and AKT3) called the AKT kinase, and which regulate many processes including metabolism, proliferation, cell survival, growth and angiogenesis. This is mediated through serine and/or threonine phosphorylation of a range of downstream substrates. Over 100 substrate candidates have been reported so far, but for most of them, no isoform specificity has been reported. AKT is responsible of the regulation of glucose uptake by mediating insulin-induced translocation of the SLC2A4/GLUT4 glucose transporter to the cell surface. Phosphorylation of PTPN1 at 'Ser-50' negatively modulates its phosphatase activity preventing dephosphorylation of the insulin receptor and the attenuation of insulin signaling. Phosphorylation of TBC1D4 triggers the binding of this effector to inhibitory 14-3-3 proteins, which is required for insulin-stimulated glucose transport. AKT regulates also the storage of glucose in the form of glycogen by phosphorylating GSK3A at 'Ser-21' and GSK3B at 'Ser-9', resulting in inhibition of its kinase activity. Phosphorylation of GSK3 isoforms by AKT is also thought to be one mechanism by which cell proliferation is driven. AKT regulates also cell survival via the phosphorylation of MAP3K5 (apoptosis signal-related kinase). Phosphorylation of 'Ser-83' decreases MAP3K5 kinase activity stimulated by oxidative stress and thereby prevents apoptosis. AKT mediates insulin-stimulated protein synthesis by phosphorylating TSC2 at 'Ser-939' and 'Thr-1462', thereby activating mTORC1 signaling and leading to both phosphorylation of 4E-BP1 and in activation of RPS6KB1. AKT is involved in the phosphorylation of members of the FOXO factors (Forkhead family of transcription factors), leading to binding of 14-3-3 proteins and cytoplasmic localization. In particular, FOXO1 is phosphorylated at 'Thr-24', 'Ser-256' and 'Ser-319'. FOXO3 and FOXO4 are phosphorylated on equivalent sites. AKT has an important role in the regulation of NF-kappa-B-dependent gene transcription and positively regulates the activity of CREB1 (cyclic AMP (cAMP)- response element binding protein). The phosphorylation of CREB1 induces the binding of accessory proteins that are necessary for the transcription of pro-survival genes such as BCL2 and MCL1. AKT phosphorylates 'Ser-454' on ATP citrate lyase (ACLY), thereby potentially regulating ACLY activity and fatty acid synthesis. Activates the 3B isoform of cyclic nucleotide phosphodiesterase (PDE3B) via phosphorylation of 'Ser-273', resulting in reduced cyclic AMP levels and inhibition of lipolysis. Phosphorylates PIKFYVE on 'Ser-318', which results in increased PI(3)P-5 activity. The Rho GTPase-activating protein DLC1 is another substrate and its phosphorylation is implicated in the regulation cell proliferation and cell growth. AKT plays a role as key modulator of the AKT-mTOR signaling pathway controlling the tempo of the process of newborn neurons integration during adult neurogenesis, including correct neuron positioning, dendritic development and synapse formation. Signals downstream of phosphatidylinositol 3-kinase (PI(3)K) to mediate the effects of various growth factors such as platelet-derived growth factor (PDGF), epidermal growth factor (EGF), insulin and insulin-like growth factor I (IGF-I). AKT mediates the antiapoptotic effects of IGF-I. Essential for the SPATA13-mediated regulation of cell migration and adhesion assembly and disassembly. May be involved in the regulation of the placental development. Phosphorylates STK4/MST1 at 'Thr-120' and 'Thr-387' leading to inhibition of its: kinase activity, nuclear translocation, autophosphorylation and ability to phosphorylate FOXO3. Phosphorylates STK3/MST2 at 'Thr- 117' and 'Thr-384' leading to inhibition of its: cleavage, kinase activity, autophosphorylation at Thr-180, binding to RASSF1 and nuclear translocation. Phosphorylates SRPK2 and enhances its kinase activity towards SRSF2 and ACIN1 and promotes its nuclear translocation. Phosphorylates RAF1 at 'Ser-259' and negatively regulates its activity. Phosphorylation of BAD stimulates its pro- apoptotic activity. Phosphorylates KAT6A at 'Thr-369' and this phosphorylation inhibits the interaction of KAT6A with PML and negatively regulates its acetylation activity towards p53/TP53.
|
||
Form |
Purified polyclonal antibody supplied in PBS with 0.09% (W/V) sodium azide. This antibody is purified through a protein A column, followed by peptide affinity purification. |
||
Storage & Stability |
Store at +4°C short term. For long-term storage, aliquot and store at -20°C or below. Stable for 12 months at -20°C. Avoid repeated freeze-thaw cycles.
|
||
Applications |
WB, IHC-P
|
||
Dilution |
WB~~1:1000
IHC-P~~1:25
|
||
Synonyms |
RAC-alpha serine/threonine-protein kinase, Protein kinase B, PKB, Protein kinase B alpha, PKB alpha, Proto-oncogene c-Akt, RAC-PK-alpha, AKT1, PKB, RAC
|
||
Images |

Western blot analysis of lysates from PC-3, Hela, rat C6 cell line (from left to right), using AKT1/2/3 Antibody (Center)(Cat. AMM08752G). AMM08752G was diluted at 1:1000 at each lane. A goat anti-rabbit IgG H&L(HRP) at 1:10000 dilution was used as the secondary antibody.
Immunohistochemical analysis of paraffin-embedded H. prostate carcinoma section using AKT1/2/3 Antibody (Center)( AMM08752G). AMM08752G was diluted at 1:25 dilution. A peroxidase-conjugated goat anti-rabbit IgG at 1:400 dilution was used as the secondary antibody, followed by DAB staining. |
||
Specification |
|||
Quantity |
|
||
| Select | Brand | Catalog No. | Product Name | Pack Size | Type | Field of Research | Specification | Quantity | Price(USD) | |
| 1 | Leading Biology | APR03440G | ITGA11 Antibody (N-term) | 100 μl | Polyclonal Antibodies |
|
$495.00 | Add Ask | ||
| 2 | Leading Biology | APR04537G | CMIP Antibody (C-term) | 100 μl | Polyclonal Antibodies |
|
$495.00 | Add Ask | ||
| 3 | Leading Biology | APR12422G | Human H4 Histamine Receptor (extracellular) Antibody | 50 μl | Polyclonal Antibodies |
|
$695.00 | Add Ask | ||
| 4 | Leading Biology | APR03844G | UBE2W Antibody (C-term) | 100 μl | Polyclonal Antibodies |
|
$495.00 | Add Ask | ||
| 5 | Leading Biology | APR04349G | HECTD2 Antibody (N-term) | 100 μl | Polyclonal Antibodies |
|
$495.00 | Add Ask | ||
| 6 | Leading Biology | APR03502G | IGHG1 Antibody (Center) | 100 μl | Polyclonal Antibodies |
|
$495.00 | Add Ask |
 Leading Biology Inc.
2600 Hilltop DR, Building G, B Suite C138
Richmond, CA, 94806
Tel: 1-661-524(LBI)-0262
Email: info@leadingbiology.com
Leading Biology Inc.
2600 Hilltop DR, Building G, B Suite C138
Richmond, CA, 94806
Tel: 1-661-524(LBI)-0262
Email: info@leadingbiology.com
Complete this form and click send to ask us a question, request a quote or simply say hello.

You have 0 item in your cart

You have 0 item in your inquiry list
